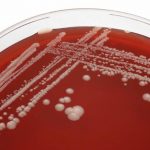

Cuando se deja de cocinar cerveza como un hobby y se comienza a pensar en la comercialización, los primeros pensamientos suelen ser: ¿Cómo paso de los 50 litros a los 1.000, 2.000? ¿Qué cantidad de fermentadores necesito? ¿Tengo algún lugar para poder instalar la fábrica? ¿Dónde voy a vender los litros que produzca? ¿Por dónde empiezo los trámites para habilitar la planta?
Normalmente la respuesta a estas preguntas viene de la mano del presupuesto del que contamos para iniciar el emprendimiento, y es lo que nos condiciona al momento de muchas decisiones. Es por ello que debemos tomar decisiones con inteligencia para hacer que nuestra inversión sea rentable y no quedarnos en el camino sin capacidad de invertir y dándonos cuenta que nos faltó comprar cosas que son vitales al momento de obtener un producto de calidad.
Por otro lado surge el interrogante en cuanto a los productos, fabriquemos cerveza, pero ¿Qué estilos? Esta decisión va acompañada de la estrategia de mercado que uno quiera adoptar. ¿Hago los estilos que todos fabrican y venden o busco estilos novedosos? ¿Cómo armo una receta diferente? ¿Qué parámetros hay que tener en cuenta? Sabemos que la calidad de nuestra materia prima influye de manera determinante en nuestro producto terminado, no solo cuando hablamos de malta, lúpulo y levadura, sino también de la fisicoquímica del agua que usaremos para cocinar.
Una vez que tenemos todo esto en claro llega el momento de comprar equipamiento, uno siempre quiere comprar el bloque de cocción más grande que le dé el bolsillo, pero esto no suele ser la mejor decisión siendo que es más conveniente invertir en fermentadores y multiplicar nuestra capacidad con menos presupuesto, pero también hay que tener en cuenta el espacio con el que contamos para tal fin y muchos otros factores que empiezan a concatenarse y de no ser tenidos en cuenta podemos encontrarnos con varios problemas en el corto plazo. Tengo lugar para 10 fermentadores, pero ¿Qué potencia necesito en mi chiller?, tengo tres proveedores que me dijeron cosas diferentes, ¿Cómo sé cuál es la opción correcta?. ¿La instalación del lugar que elegí es monofásica o es trifásica? ¿Cuánto más tengo que gastar en accesorios, válvulas, cañerías, aislación, glicol, etc.?
Ahí notamos que mientras más nos introducimos en los detalles de las elecciones que en un principio parecían simples, son en realidad más complejas de lo que pensábamos.
¿Debería invertir en mí y en capacitarme previo a tirarme a la pileta con los ojos cerrados? Sí, es algo necesario si queremos que nuestro tiempo y nuestra inversión den frutos. Al emprender a mayor escala no podemos arriesgarnos a arrancar con el pie izquierdo, a «quemar» a los clientes potenciales y a despilfarrar nuestra inversión tomando decisiones que no sean las óptimas para cada caso.
En UTN.BA entendemos eso y es por ello que creamos el Centro de Capacitación e Investigación en Industria Cervecera dentro del cual se encuentra la flamante Diplomatura en Microcervecerías donde se abordan en profundidad todos los temas necesarios desde el diseño y montaje de la fábrica, pasando por la elaboración y culminando en la comercialización de nuestro producto. Pueden encontrar el programa de la diplomatura, que arrancará el 27 de febrero de 2019, y toda la información pertinente en http://bit.ly/DiploCervezaUTNBA.